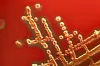

Ny metode avslører bakterier
Pål Trosvik har utviklet nye metoder for å forstå hvordan bakteriesamfunn fungerer. – Først når vi forstår dette, kan vi kontrollere og manipulere dem, sier han.
Denne artikkelen er over ti år gammel og kan inneholde utdatert informasjon.

Bakteriene lever i kompliserte samfunn, det være seg i jord, vann eller i menneskekroppen.
For eksempel består den normale humane bakterieflora av så mye som 1014 bakterieceller – 100 ganger så mange som det finnes menneskeceller i kroppen.
En voksende mengde litteratur dokumenterer den store betydningen disse mikrobene har for helse og sykdom. Men vår viten om deres økologi er fortsatt svært mangelfull.
Gjennom et tverrfaglig samarbeid mellom Nofima Mat (tidligere Matforsk) og Centre for Ecological and Evolutionary Synthesis (CEES, Senter for Fremragende Forskning ved Biologisk Institutt ved UiO) har Pål Trosvik utviklet nye metoder for å måle forekomsten av ulike mikrober i komplekse samfunn.
Dette gir helt nye muligheter til å forstå hvordan bakteriesamfunn fungerer, kunnskap av potensielt stor verdi for eksempel i forebygging og behandling av infeksjoner.
Nytt bruksområde

I økologiske studier av planter og dyr er analyse av tidsseriedata mye brukt.
Tidsserieanalyser kan gi informasjon om hvilke forhold som styrer utvikingen av økosystemer, for eksempel hvorfor det er lemenår med jevne mellomrom eller mekanismen bak kollapsen i en fiskebestand.
Å bruke denne typen analyser til å studere mikrobenes verden er helt nytt.
– Noe av det viktigste jeg har oppnådd er å knytte fagdisiplinene økologi og mikrobiologi sammen. Jeg tror vi har mye å hente på samarbeid, sier Pål Trosvik.
Teller det usynlige
Populasjonsdata på mikrober er vanskelige å oppdrive.
Mens økologene fysisk teller hjort og torsk, er bakterier i praksis usynlige, vanskelige å skille fra hverandre, og de har ekstremt kort generasjonstid (så lite som 10 minutter under gunstige forhold).
– Metodene vi har utviklet gjør det mulig å følge bakteriesamfunn gjennom tid på en relativt hurtig, billig og enkel måte. De er basert på simultan registrering av DNA-molekyler som kan skille mellom de ulike medlemmene av et samfunn.
– Så analyseres DNA-signalene ved hjelp av regnemetoder som normalt brukes kjemi, forklarer Trosvik.
De snille vinner over de slemme

Metodene er testet både i infeksjonssituasjoner for kylling og laboratoriekulturer av tarmbakterier.
Analyse av de resulterende tidsseriene har gjort det mulig å danne hypoteser om hvordan bakteriesamfunn fungerer.
– Dette er viktig for å kunne forebygge sykdommer som følge av endringer i kroppens naturlige bakterieflora i tarmen, sier Trosvik.
Et eksempel: I en studie så han på samspillet mellom representanter for fire av de viktigste divisjonene av tarmbakterier hos mennesker, blant annet Clostridium Perferingens (vanlig årsak til matvarebårne sykdommer) og Bacteroides thetaiotaomicron (involvert i en rekke fysiologiske funksjoner hos mennesker).
Det viste seg at den interne konkurransen mellom bakteriene førte til at den ”slemme” clostridium-bakterien ble begrenset, samtidig som B.thetaiotaomicron var gunstig for vekst av ’helsebakterien’ Bifidobacterium longum (som kan finnes i yoghurtprodukter o.l.).
– I utgangspunktet kan metoden brukes på alt som har DNA, som man vil telle og som forekommer i blandinger. Jeg teller det relative mengdeforholdet, og det er forandringen over tid som er det viktige i slike tidsserieanalyser, sier doktoranden.
Bakgrunn:
1. september disputerer Pål Trosvik for sin doktorgrad.